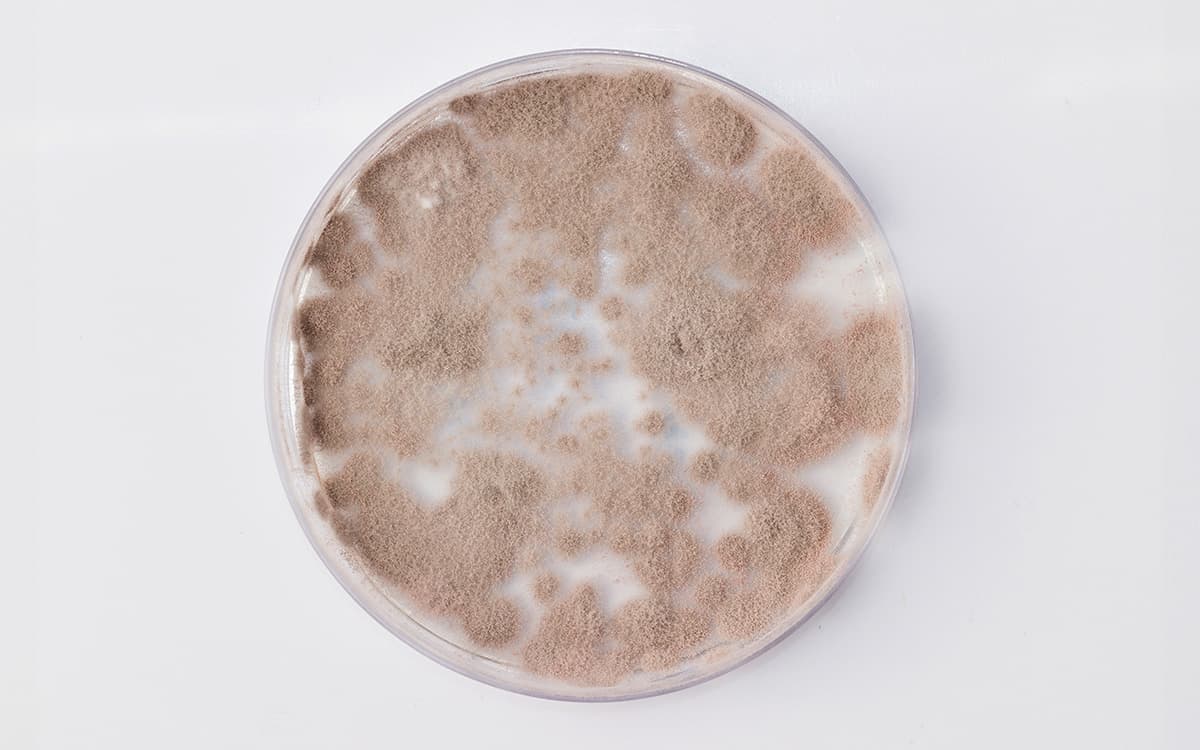

O controle biológico pode ser visto de três formas diferentes: como um campo de estudo para diferentes áreas, como um fenômeno natural – pois quase todas as espécies possuem inimigos naturais que atuam no controle da população -, ou como uma estratégia sustentável de controle de pragas e doenças da agricultura por meio de parasitoides, predadores e patógenos.
Podemos classificar o controle biológico em 3 tipos:
- Natural: feito pelos inimigos naturais já existentes no ecossistema, o que acarreta no equilíbrio da natureza.
- Clássico: controle a longo prazo. É realizado pela introdução de poucos indivíduos para controle de pragas exóticas. As liberações são realizadas por uma ou mais vezes no mesmo local. É aplicado em culturas semiperenes e perenes.
- Aplicado: ocorre a partir da liberação de populações de insetos criados em laboratório. Tem ação rápida, controlando a praga de forma semelhante aos produtos químicos.
Os parasitoides, predadores e patógenos podem ser insetos, ácaros, fungos, bactérias vírus, ou nematoides. Todos esses organismos podem ser chamados de agentes biológicos ou, inimigos naturais.

Controle biológico: uso de organismos vivos para o controle de determinada praga, diminuindo sua população e deixando-a menos danosa.
Praga: qualquer espécie, linhagem ou biótipo de uma planta, animal ou agente patogênico, daninho ou potencialmente daninho para os vegetais ou animais (EMBRAPA).
Agentes biológicos são organismos benéficos capazes de diminuir a população de uma praga ou doença, para que não haja danos econômicos na lavoura.
Esses agentes fazem parte do controle biológico de pragas e doenças e são peças fundamentais no Manejo Integrado de Pragas, o MIP. Identificar, estudar suas características e o potencial de controle de cada agente biológico requer dedicação e muito tempo dos pesquisadores que trabalham nessa área.
Inimigos naturais: produtos para controle biológico
A primeira etapa no processo de desenvolvimento de produtos para o controle biológico é o levantamento e coleta de inimigos naturais na natureza. As pesquisas começam pela reprodução do ambiente natural e avaliação das relações que ocorrem entre os organismos vivos na natureza.
A partir do monitoramento, os insetos ou o resultado da atuação dos microrganismos nas pragas alvo são coletados e levados para os laboratórios das empresas de controle biológico, institutos de pesquisa ou universidades.
Nos laboratórios são desenvolvidos os processos de isolamento, identificação, caracterização e avaliação da eficiência dos organismos como agentes de controle biológico. Essa etapa da pesquisa pode durar um longo período, passando por anos de estudos.
Quando os pesquisadores conseguem as respostas e os resultados dos testes realizados, é iniciada a etapa do desenvolvimento de produtos à base dos agentes de controle biológico. Nessa fase, os produtos são levados à campo para testes de eficiência e segurança. Os testes a campo precisam ser realizados por mais de uma safra, para que os resultados sejam confiáveis.
Depois de alguns anos, desde o monitoramento dos agentes biológicos, até o final dos testes de campo, os produtos precisam ser registrados e avaliados peço Ministério da Agricultura, Pecuária e Abastecimento (MAPA), Instituto Brasileiro do Meio Ambiente e dos Recursos Naturais Renováveis (Ibama), e pela Agência Nacional de Vigilância Sanitária (Anvisa). A avaliação do produto por esses três órgãos governamentais os classifica quanto ao impacto que podem causar ao meio ambiente e quanto as recomendações de uso mais seguras.
Produtos de controle biológico à base de fungos
Os fungos são um grupo especial de microrganismos para o controle biológico. Essa diferenciação ocorre porque os fungos têm a forma de controle ativa, ou seja, não precisam ser ingeridos para que possam controlar os insetos.
Os fungos foram os primeiros patógenos utilizados para o controle de insetos. Mais de 700 espécies de fungos de aproximadamente 90 gêneros, são responsáveis pelo controle de insetos em todo o mundo.
Um dos fungos mais utilizados no controle biológico é o da espécie Metarhizium anisopliae. Esse fungo foi isolado de um coleóptero que causava danos em cereais em 1879. O Anisoplia austriaca, foi descrito por Sorokin anos mais tarde, em 1883.
No Brasil o M. anisopliae é utilizado desde 1965 para o controle da cigarrinha da cana. O fungo também tem efeito de controle em outros insetos, como a broca da cana, percevejo da soja, broca do café, entre outros.
Os produtos à base de M. anisopliae são formulados a partir dos conídios do fungo. Para o desenvolvimento dos produtos, são necessárias pesquisas sobre a viabilidade e virulência do microrganismo. A viabilidade dos conídios precisa ser maior que 85%, em sua germinação.
Conídios: são os esporos assexuados dos fungos. É o modo mais comum da reprodução assexuada dos fungos.
Outras pesquisas sobre armazenamento, temperatura ideal de armazenagem, embalagens e os tipos de formulação também são realizadas. Para os produtos à base de fungos, as formulações podem ser:
- Pó e Pó molhável.
- Granulados.
- Óleo emulsionável.
- Pasta.
- Encapsulados.
- Iscas.

Outras espécies de fungos importantes no controle biológico, são: Beauveria bassiana; Verticillium lecanii; Neozygites floridana; Neozygites aphidis; Nomuraea rileyi; Hirsutella thompsonii; Colletotrichum gloeosporioides; Fusarium spp.; Aschersonia aleyrodis.
Produtos de controle biológico à base de bactérias
As bactérias têm sido amplamente estudadas para uso no controle biológico. Esse grande interesse surgiu por conta da possibilidade de fabricação desses microrganismos por meio do processo de fermentação. Além disso, as bactérias representam o maior grupo de entomopatógenos, com um grande número de produtos formulados sendo comercializados em todo o mundo.
As bactérias entomopatogênicas podem ser esporulantes ou não-esporulantes, anaeróbias obrigatórias ou facultativas e sua infecção ocorre por via oral. As bactérias que possuem esporos, possuem cristal proteico, composto por proteínas tóxicas, que exercem efeito sobre os insetos-praga.
Organismos anaeróbios: são organismos que não necessitam de oxigênio para seu crescimento e desenvolvimento.

Bacillus thuringiensis (Bt)
O Bacillus é o principal grupo de bactérias, e é responsável pelo maior número de produtos biológicos comerciais. Assim como para os produtos à base de fungos, as pesquisas iniciais precisam ser realizadas com foco em: estabilidade, armazenagem, temperatura, formulação, entre outras.
O Bacillus thuringiensis (Bt) é a espécie mais conhecida e utilizada como bactéria de controle biológico. Atualmente existem 25 produtos comerciais registrados que usam o Bt como princípio ativo, em diferentes formulações: pó molhável; suspensão concentrada; concentrado emulsionável; granulado dispersível, e outras.
Cadastre-se e receba conteúdos exclusivos da Pragas.com
Produtos de controle biológico à base de vírus
Os vírus patogênicos a insetos estão se tornando um importante nicho de produtos de controle biológico. Dentro deste complexo grupo de vírus entomopatogênicos, grande parte das pesquisas e do desenvolvimento de produtos é focado nos chamados baculovírus.
Os baculovírus são um grupo de vírus patogênicos a artrópodes, pertencentes à família Baculoviridae, que atacam principalmente insetos das ordens Lepidoptera, Diptera e Hymenoptera.
Os primeiros registros destes vírus foram descobertos em manuscritos chineses por volta do ano 1500, e relatam a influência deles em lagartas doentes do bicho da seda (Bombix mori). O avanço de pesquisas acerca do uso da natureza viral da doença no manejo de pragas só se iniciou em 1947. Nos últimos 70 anos, já foram isoladas mais de 400 espécies de vírus com potencial para uso no controle de pragas.
Sucesso do vírus no Brasil
Um grande exemplo de sucesso de uso de vírus para controle biológico no Brasil, é o vírus Anticarsia gemmatalis MNPV como forma de controle da lagarta da soja. Mais de 2 milhões de hectares foram tratados por baculovírus no país.
Os produtos à base de baculovírus são seguros, específicos para determinada espécie de praga e de fácil formulação e aplicação. Segundo dados fornecidos pelo AGROFIT, o Brasil possui pelo menos 17 produtos comerciais à base de baculovírus registrados atualmente. Com isso, novos produtos estão ganhando espaço no mercado, ajudando a promover uma agricultura mais sustentável.
Insetos como produtos para controle biológico
O princípio básico do controle biológico à partir de insetos como inimigo natural é simples: inseto se alimentando de inseto. Esses inimigos naturais podem ser predadores ou parasitoides, e são chamados de entomófagos.
De maneira geral, os entomófagos precisam ter as seguintes características:
- adaptabilidade às mudanças das condições físicas do ambiente.
- especificidade ao hospedeiro/presa.
- alta capacidade de crescimento populacional com relação a seu hospedeiro/presa.
- alta capacidade de busca do hospedeiro/presa.
- sincronização sazonal com o hospedeiro/presa.
- sobrevivência nos períodos de ausência do hospedeiro/presa.
- mostrar densidade recíproca (mudança populacional).
Os insetos são multiplicados e criados em laboratórios específicos e após, são vendidos em unidades
Utilizando insetos como inimigos naturais nas lavouras
Os insetos de controle biológico são soltos nas lavouras de forma estratégica e programada. Essa estratégia é elaborada junto com o técnico da empresa de criação dos insetos, e considera a densidade populacional do inseto-praga para a regulação e controle dos insetos.
Um produto muito utilizado hoje no Brasil é a vespa Trichogramma galloi, que tem muita eficiência no controle da broca da cana-de-açúcar. A vespa ataca os ovos da mariposa da broca, inoculando seus próprios ovos dentro dos ovos da praga alvo – que também chamamos de hospedeiro -, impedindo que a lagarta, que ainda está em formação, ecloda e se alimente das plantas.
Mesmo sendo à base de insetos, esse tipo de produto biológico precisa passar por toda a pesquisa e processo de registro e validação, como qualquer um dos outros produtos. Atualmente existem seis produtos registrados para controle biológico que contam com a vespa T. galloi como ingrediente ativo.
Insumos biológicos: peças importantes para pesquisas sobre controle biológico
A Pragas.com é uma empresa de soluções inovadoras que acredita no potencial das descobertas que vem acontecendo no país em torno do controle biológico. Para dar suporte a toda uma cadeia em larga expansão, hoje a empresa fornece insumos biológicos para facilitar a padronização dos processos de desenvolvimento de produtos biológicos, tornando essa atividade cada vez mais rentável e sustentável.
Para conhecer toda linha de insumos biológicos da Pragas.com, acesse nosso portfólio:
https://pragas.com.vc/produtos/insumos-biologicos
Para falar com um especialista:
(19) 3413-0026 | 98263-2021
contato@pragas.com.vc